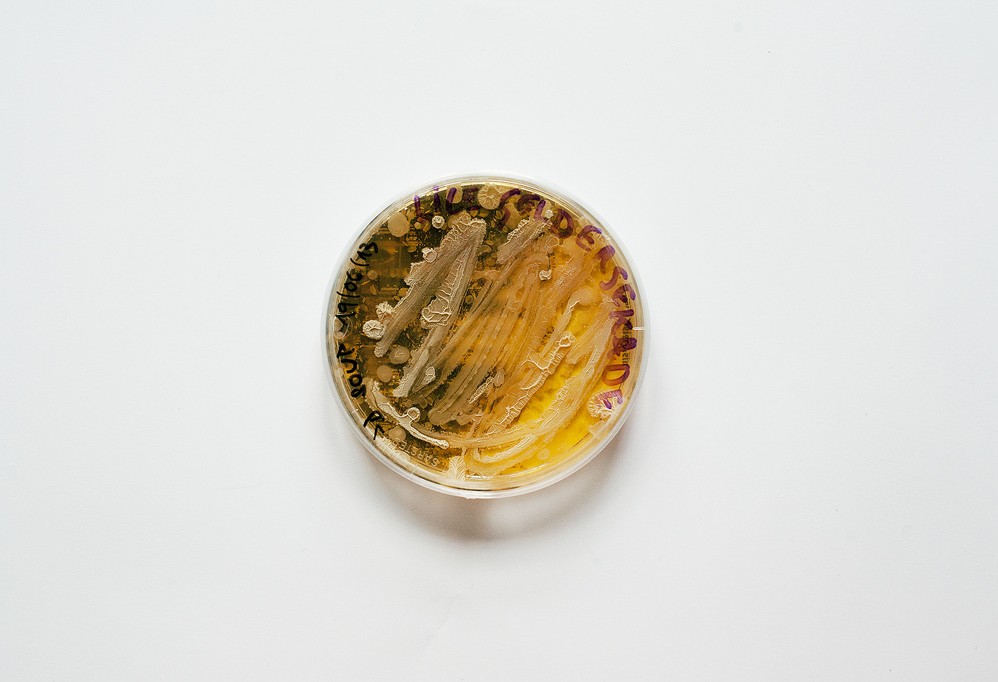

Microbiology, science of the invisible
Microbiology, the science that studies microscopic organisms, was born when Leeuwenhoek first saw these teeny tiny beings under a microscope that he designed, in the late 1600’s. After his discovery, many theories where formulated regarding the origin of these organisms. One of them was that they could generate from almost anything, known as the Spontaneous Generation Theory. Many scientists presented evidence that disprove this idea, but it wasn’t until Pasteur designed an irrefutable experiment that once and for all, spontaneous generation was no longer valid. After this, the study of microorganisms started advancing thanks to the development of better microscopes and techniques that allowed the isolation of microbes.
- Important notification about information and brand names used in this slideshow!
- Photo courtesy of USDAgov by Flickr : www.flickr.com/photos/usdagov/8496686885/
- WAINWRIGHT, M. 2003. An alternative view of the early history of microbiology. Advances in Applied Microbiology, Vol 52, 52, 333-355.

What are microbes?
Microbes, or microorganisms, are small organisms that can only be seen through the lens of a microscope. They are so tiny that the naked eye can’t really detect them, unless they are all clustered together somewhere, like on the tiles of your bathroom or on an old bread. Microbes have inhabited the Earth even before any vertebrate way of life did. You can find them anywhere: in the air, in the soil, in the food, in the surfaces of things and even in your skin and inside your intestine. Most of the microorganisms on Earth are not harmful to humans, but there is a small percentage that can cause disease. Microbes are divided into several groups to make it easier for people to study them. These are bacteria, archaea, protists, fungi and plants.

Pathogenic and non-pathogenic microbes
95% of all microorganisms that inhabit the Earth are harmless. The rest can cause different diseases when infecting other animals, including humans. When a microbe causes illness in humans it is classified as a pathogenic agent. For example, the bacteria that cause cholera, Vibrio cholerae, would be classified as pathogenic; while the bacteria present on the surface of a leave, in the forest, would be non-pathogenic. Sometimes, a non-pathogenic microbe can become pathogenic, depending on the person's immune system. Several conditions can make the immune system to stop working, allowing opportunistic microbes to cause harm, when they would normally won’t.

The bacterial world
Bacteria are the simplest microorganisms that have been identified. They are part of the prokaryote classification because their DNA is not confined into a nucleus. You can find bacteria everywhere, even in the most hostile parts of this world. Bacteria have different shapes, and they are basically classified on how they look under the microscope. Some bacteria are round, like a tennis ball, and they can be found alone or in clusters. Because of their round shape, they are known as cocci. Some other types of bacteria look more like a sausage, which is why they are named bacilli. There are some bacteria that are neither cocci nor bacilli, but can look like a bean, a serpentine, a comma, or they simply have an irregular shape.

Are viruses microbes?
There is a very intense debate around viruses. It has been hard to establish whether they are living organisms or not, which is why they aren't considered in the general classification of microorganisms. Why? Well, viruses depend on a host to replicate. They literally use their host cells to “live” and produce more viruses. Without a host, viruses are only considered protein particles that are not active. So, viruses are on the edge of being considered living or non-living entities. Viruses are smaller than bacteria and are conformed by a capsid that serves as a container for their genetic material. When they infect a host cell, they insert their genetic material into the host, altering the host's functions.

Bacteria in our body
We have bacteria all over us, and also inside us. It would be impossible to isolate us from bacteria, unless we lived in a sterile environment for the rest of our life, like the bubble man. Bacteria present in our body is known as normal body flora and is 10 times greater in number than the number of cells that are in our entire body! Even if it sounds strange, bacteria in our body helps us stay healthy and fight against other bacteria that could potentially harm us. Bacteria are basically present on all our body surfaces, both in the inside and outside. Bacteria populate our digestive tract; they help is digest nutrients and maintain a certain digestive environment. There are also bacteria on our skin, inside our mouth, our nose and the rest of the respiratory tract.
- Important notification about information and brand names used in this slideshow!
- Photo courtesy of Garry Knight by Flickr : www.flickr.com/photos/garryknight/8448423132/
- http://www.microbiologyonline.org.uk/about-microbiology/microbes-and-the-human-body http://textbookofbacteriology.net/normalflora.html

When bacteria goes bad
Very few bacterial genera can cause diseases to humans. When bacteria is present in our body, we say that we have a bacterial infection, but this doesn’t necessarily mean that these bacteria are making us sick. Bacteria cause disease when they alter our vital functions and cause damage to our organs. So, bacterial infection is not the same as bacterial disease. The most common illnesses caused by bacteria affect the respiratory and the digestive system. However, there are bacteria that can also cause diseases of the skin, the ear and the urinary tract, for example. Treatment for bacterial illnesses relies on antibiotics, which kill bacteria through different mechanisms.
- Important notification about information and brand names used in this slideshow!
- Photo courtesy of Umberto Salvagnin by Flickr : www.flickr.com/photos/kaibara/2072160194/
- http://www.microbiologyonline.org.uk/about-microbiology/microbes-and-the-human-body/microbes-and-disease http://textbookofbacteriology.net/pathogenesis.html

Viruses that cause disease
Viruses can also cause infections and disease. Viral diseases are usually very contagious, since viruses can be spread easily through body fluids and even by being in contact with contaminated surfaces or clothes, like bed sheets. Nowadays, one of the most dangerous viral infections is HIV, which can later evolve to AIDS. This disease affects the immune system of patients because the HIV virus infects and kills the immune cells, making patients vulnerable to other diseases. Viral diseases are treated with antiviral drugs; also, preventive actions, such as vaccination, have played a major role in the control of lethal viral diseases, like smallpox and poliomyelitis.
- Important notification about information and brand names used in this slideshow!
- Photo courtesy of ZEISS Microscopy by Flickr : www.flickr.com/photos/zeissmicro/6908581125/
- www.ncbi.nlm.nih.gov/books/NBK8149/

Viruses and gene therapy
Inherited diseases are usually caused by mutations in our genes that alter the normal functions of cells. These mutations can abnormally turn off genes, leading to an underproduction or no production at all of a vital protein. Gene therapy was designed to try to compensate for this lack of proteins in specific diseases, such as spinal muscular atrophy, by inserting the normal gene into the cells of the patient. How do scientists do this? They use viruses as carriers of the normal gene. As discussed earlier, viruses can insert genetic material into the cells of the host. Gene therapy is based on this ability of viruses to carry and insert the normal gene into the patient’s DNA, so that the protein is produced again, normally.
- Important notification about information and brand names used in this slideshow!
- Photo courtesy of UC Davis College of Engineering by Flickr : www.flickr.com/photos/ucdaviscoe/9731984515/
- ghr.nlm.nih.gov/handbook/therapy/procedures
Bacteria in industry
Ever since the discovery of the microscopic world, scientists have learnt about microbes and how to grow them and use them to produce several products. Bacteria are used in industry to produce food, like yogurt, fuels, solvents, vaccines, antibiotics, probiotics, enzymes and insecticides. Culturing bacteria has become one of the main techniques in biotechnology, and even when they are the simplest microorganisms on Earth, their use in industry requires a very deep understanding of their biochemical properties. All this knowledge has allowed scientists to find techniques to genetically modify bacteria to make them, for example, mass produce a certain substance.
Your thoughts on this
Loading...